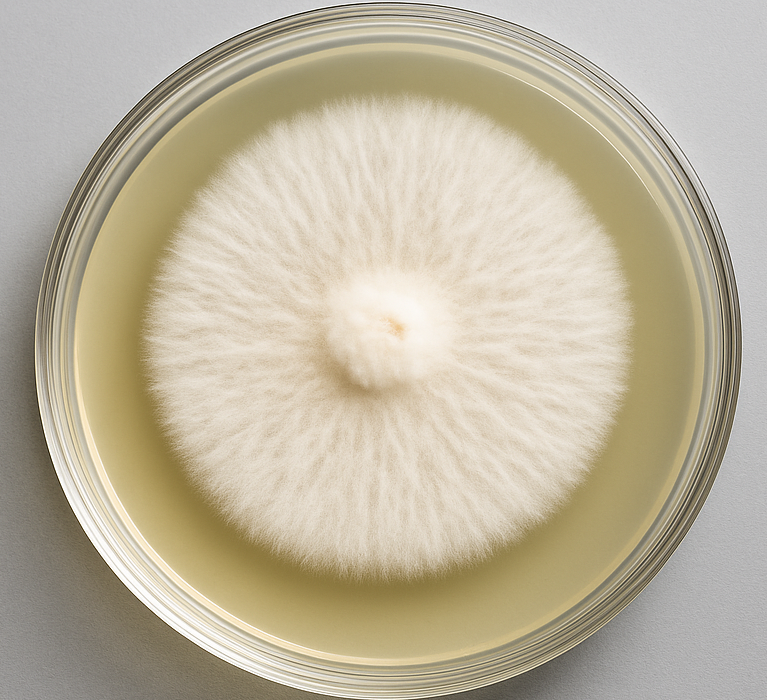
Stropharia rugoso-annulata Wine Cap Mushroom Culture
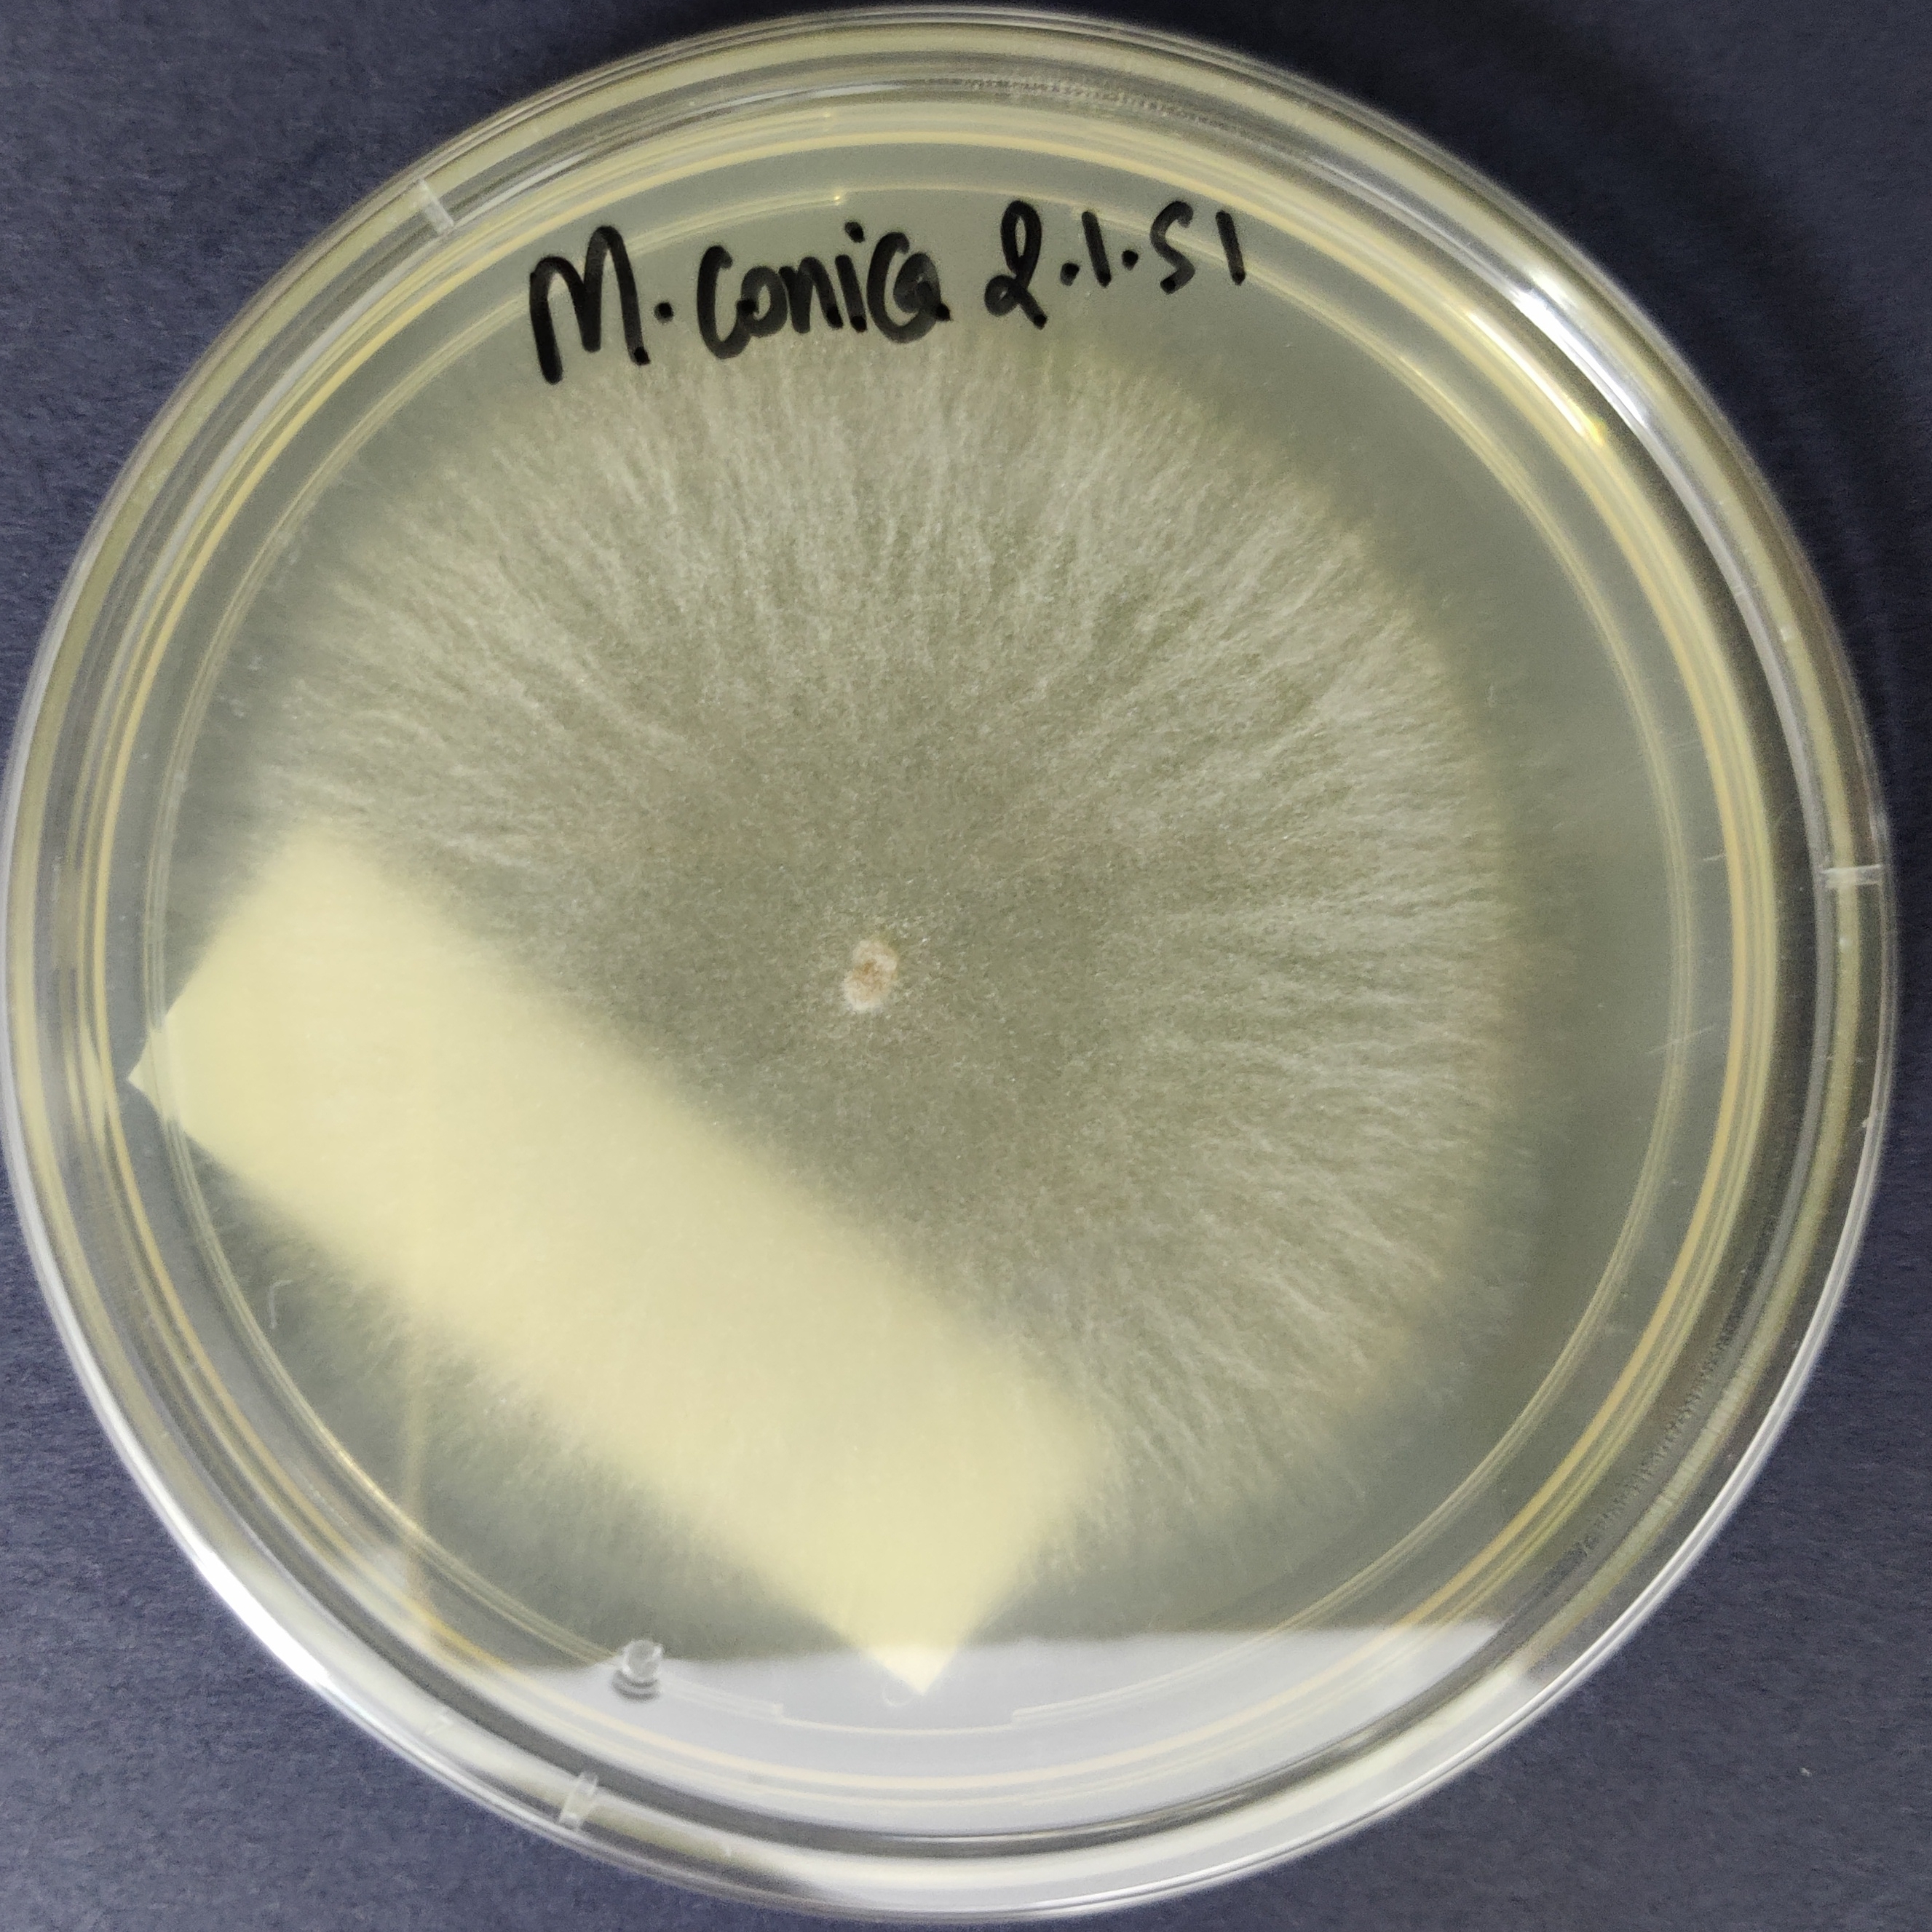
Morel Mushroom Culture Plate (Morchella conica)

Ceriporus squamosus Dryad’s Saddle culture
₹2,500.00
You’re now subscribed to price tracking for this product. We’ll notify you if the price drops.
Explore the versatile and nutritious world of Ceriporus squamosus i.e. Dryad’s Saddle Culture Plate. Also known as Dryad’s Saddle or Polyporus squamous. Meticulously cultured in Agripie’s advanced laboratories, this pure culture plate ensures vigorous, contamination-free mycelium, ideal for enthusiasts, commercial growers, and mushroom hobbyists alike.
Known for its distinctive saddle-shaped, scaly fruiting bodies, Dryad’s Saddle is valued for its delightful taste and potential health benefits. Frequently used in gourmet culinary applications, Ceriporus squamosus mushrooms possess antioxidant properties and are cherished for their nutritional value and unique savory aroma.
Why Choose Agripie’s Cultures ?
✅ India’s Largest Mushroom Culture Bank: Agripie has a vast collection of 38 species of gourmet, specialty and medicinal mushrooms, accounting a total of 70+ strains and varietries.
✅ Ideal For: Perfect for beginners and commercial cultivators, Academics and Research, Industrial applications, etc.
✅ Culture Formats: Cultures available in Agar Plate, Syringe, Long-term storage Format – choose as you need.
✅ Unmatched Purity of Cultures: Our cultures are contamination-free and cultivated on antibiotic-free media.
✅ Proudly Made in India 🇮🇳: Grown and tested in Agripie’s premium facility.
| Weight | 0.1 g |
|---|
Only logged in customers who have purchased this product may leave a review.

Reviews
There are no reviews yet.